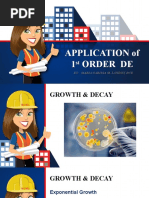

0% found this document useful (0 votes)
506 views8 pagesApplications of Differential Equations
Differential equations are used extensively in science and engineering to model dynamical systems. The most common differential equation is the natural growth equation, dy/dt = ky, where k is the growth or decay rate constant. This equation models exponential growth (k > 0) or exponential decay (k < 0). Examples where exponential growth and decay occur include bacterial population growth, radioactive decay, and electric circuits.
Uploaded by
Rosei DuitesCopyright
© © All Rights Reserved
We take content rights seriously. If you suspect this is your content, claim it here.
Available Formats
Download as PDF, TXT or read online on Scribd
0% found this document useful (0 votes)
506 views8 pagesApplications of Differential Equations
Differential equations are used extensively in science and engineering to model dynamical systems. The most common differential equation is the natural growth equation, dy/dt = ky, where k is the growth or decay rate constant. This equation models exponential growth (k > 0) or exponential decay (k < 0). Examples where exponential growth and decay occur include bacterial population growth, radioactive decay, and electric circuits.
Uploaded by
Rosei DuitesCopyright
© © All Rights Reserved
We take content rights seriously. If you suspect this is your content, claim it here.
Available Formats
Download as PDF, TXT or read online on Scribd
/ 8